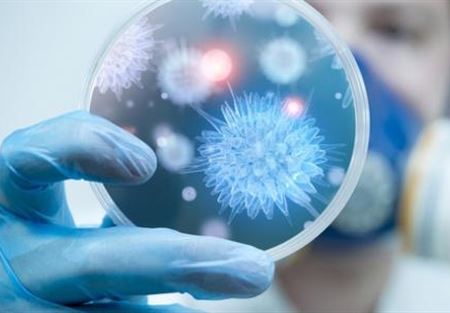

حذّر علماء أميركيّون من بكتيريا خاصة، اكتشفوها صدفة، قادرة على التهام الأجهزة الإلكترونيّة لو تسللت إلى مكاتبنا.
يمكن للبكتيريا أن تكيّف نفسها للعيش في الأحوال المختلفة، منها ما يعيش في الدخان فائق السخونة المتصاعد من البراكين، وآخر يعيش في الصقيع السبيري، ونوع ثالث يعيش على بعد كيلومترات في أعماق البحر، ويتحمّل ضغط الماء الهائل.
باكتيريا عجيبة
أعلن العلماء اليابانيون قبل فترة قصيرة عن أكتشاف بكتيريا تلتهم البلاستيك، وربّما تكون الحل لمشكلة تراكم البلاستيك على كوكب الأرض. وكشف الاميركيون عن بكتيريا تتخصّص في التهام مركبات الكروم السامة. ويبدو أن هناك نوعًا جديدًا يعتاش على السيليكون المستخدم في صناعة الأجهزة، كما يحذّر العلماء الأميركيّون.
وفي حال تسلل هذه البكتيريا إلى حياتنا اليومية، يمكن أن تصبح الأجهزة الإلكترونية معدية فعلًا، وقد يكون سبب عطل الموبايل أو اللابتوب مستقبلًا هو التهاب بكتيري حادّ بدلًا من الفيروسات المعروفة في الانترنيت.
وحذر الباحث الاميركي جان فول على صفحات مجلة "نيدرلاند بوبليك اومريوروب" الهولندية العلمية، من السرعة التي تتكاثر فيها هذه البكتيريا، مشيرًا إلى أن فريق العلماء الذي أكتشفها لا يعرف من أين أتت.
وأطلق فول على هذه البكتيريا اسم "برايموس اريلوس" Primus arilus، وقال انها تلتهم مادة السيليكون التي تدخل في صناعة الأجهزة الإلكترونية السائدة اليوم، وخصوصًا في صناعة الشرائح الإلكترونية التي تشغل هذه الأجهزة. وهذه الخاصية تجعل منها بكتيريا خطرة على حياة الأجهزة.
ومعروف أن السيليكون نصف معدن ونصف موصل، يشكل نسبة عالية من الرمل، ومن مكونات التربة في الكرة الأرضية، كما أن هناك 20 غرامًا منه في كل كيلوغرام من جسم الإنسان، وتبدأ هذه النسبة بالتراجع مع تقدم العمر. ويعرف العالم أكثر من 500 نوع من أنواع السيليكون.
كشف بالصدفة
تكسب بكتيريا برايموس اريلوس الطاقة التي تحتاجها للتكاثر والنمو من خلال تفكيك عنصر السيليكون، كما كشفت الفحوصات المجهرية عليها. وتلتهم هذه البكتيريا كل الأشكال التي نعرفها للسيليكون، بما فيها الرمال الاعتيادية، والسيليكون في الأجهزة، والكوارتز الذي يعتبر من أنواع السيليكون الفائقة النقاء.
يقول فول إنهم عثروا على نوع مجهول من البكتيريا بينما كانوا يفحصون في المختبر كتلة من جليد القطب الشمالي. وحينما حاولوا استنبات هذه البكتيريا في المستنبات المختبرية، التي تحتوي على مواد تتغذى عليها البكتيريا المعروفة، فشلت البكتيريا الجديدة في الحياة.
وحدثت "العدوى" صدفة بينما كان أحد العاملين في المختبر يجرب استنبات البكتيريا، لأن بعضها انتقل إلى كومبيوتر قريب. تعرض الكومبيوتر بعدها إلى عدة حالات عطل، ثم توقف عن العمل، وحينما فحص الباحثون شرائح الكومبيوتر الإلكترونية تحت المجهر وجدوا أن هذه البكتيريا الغريبة التهمت السيليكون في جزء من هذه الشرائح.
خشية العدوى
عزل الباحثون الكومبيوتر المصاب في غرفة معزولة تمامًا خشية أن تتسلل البكتيريا إلى باقي الأجهزة في المختبر. وأطلقوا عليها اسم برايموس اريلوس، وقرروا تحذير العالم من مخاطر انتشارها في الحال، على أن ينشر التقرير التفصيلي عنها لاحقًا في المجلات العلمية.
وستكون الخطة التالية هي كشف التركيبة الجينية الكاملة، والأحماض النووية، لهذه البكتيريا بغية كشف سر"عشقها" للسيليكون، وبهدف البحث عن مضاد حيوي لها.
سبق لعلماء البيئة أن حذّروا البشر من فرط استغلال السيليكون الذي يدخل في البناء وفي الصناعة الإلكترونية وفي إنتاج مستحضرات التجميل وفي التعليب وتجفيف الفواكه...إلخ، وإذا كانت الشريحة الإلكترونية تستهلك القليل من السيليكون، فإنّ بيتًا صغيرًا يحتاج إلى 200 طن من الرمل الذي يشكل ثاني أوكسيد السيليكون معظمه. ويعتقد هؤلاء العلماء أن الحروب القادمة ستكون بسبب الرمل، بعد أن سادت لعقود بسبب النفط والماء.
تــابــــع كــل الأخــبـــــار.
إشترك بقناتنا على واتساب

Follow: Lebanon Debate News

الـــمــــزيــــــــــد
الـــمــــزيــــــــــد




